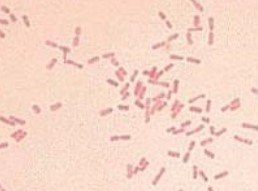

食品中有害的细菌有哪些
1、沙门氏菌--无芽孢兼性细菌
中毒原因:引起的食物中毒是因为摄入沙门氏菌的活菌,属于感染性中毒。可能是内毒素对肠道壁的刺激引起的
症状:恶心、呕吐、腹泻、全身发热
分布:主要来源于肠道,如家禽、家畜的肠道
2、大肠杆菌----有的有害,有的无害
中毒原因:肠出血性大肠杆菌产生肠毒素,造成肠出血
症状:主要症状是突发性腹痛, 危及肝、肾。 在小儿中常导致溶血性尿毒综合征,威胁生命
分布:被感染的病人的粪便中找到, 由病人食品直接接触所传播。 也可经由空气或水传播。

3、副溶血性弧菌--分布极广的一种近海嗜盐性菌
中毒原因:但通常是在吃了感染的食物后
症状:主要症状为腹痛、腹泻、呕吐、发热、发及胃痉挛等。
分布:副溶血性弧菌常可在海洋生物及海水中找到, 能使人的红细胞发生溶血而致病。 在非沿海地区则常由于食用带菌的腌菜、腌鱼、腌肉等含盐食品而发生中毒。

4、金黄色葡萄球菌---在有氧或无氧的环境下皆可存活
中毒原因:食入带有毒素的食物
症状:主要症状为恶心, 剧烈反复呕吐,上腹部剧烈疼痛,腹泻和水样便, 体温一般正常。
分布:引起葡萄球菌食物中毒的食物有奶、肉、禽、蛋、鱼及其制品,主要有:奶油蛋糕、奶茶、荷包蛋、糯米凉糕、凉粉、高蛋白食品制作的剩菜、布丁、鸡蛋沙及奶酪等金黄色葡萄球菌是化脓性球菌之一, 化脓部位常常是食物中毒病原的生地。 如疮疖、痈、痘、急性呼吸道感染,口腔、鼻腔炎症的患部,患有乳房炎乳牛的乳,带有化脓性感染的牲畜肉。 操作人员在工作间隙不经意抓搔、掏鼻、抠耳后未经消毒接触直接入口食品,易造成病菌传播。

5、肉毒梭菌----肉毒梭状芽孢杆菌
中毒原因:它所产生的毒素称为肉毒毒素,是现今已知的毒素中毒性最剧烈的一种。 被食入后, 产生神经麻痹症状。
症状:肉毒毒素中毒时引起运动神经麻痹、脑神经麻痹,却无常见的呕吐、腹泻等症状。 发病初期症状为头晕、头疼、口干,继而吞咽困难, 咽喉肌和膈肌麻痹, 丧失反应能力。
分布:肉毒梭菌为腐生菌,广泛分布于土壤和动物粪便中以及植物和水体中,借其芽孢可以长期存活。 污染食品后,在适宜条件下 可以大量繁殖并产生毒素。引起中毒的食品多因受到带菌的土壤、尘埃或受到粪便污染所致。 世界各地中毒情况也因饮食习惯、膳食组成、制作工艺的不同而有差异。 如美国常见于蔬菜和水果罐头, 欧洲常见于火腿、腊肠和其他肉制品, 日本、前苏联常见于鱼制品。 在我国多由植物性食品, 如臭豆腐、豆豉、豆酱、面酱等家庭作坊式 自 制 发 酵 食 品 引 起, 也 见 于 肉 类 和 其 他 食 品, 如 罐 头、 腊 肉、 熟肉等。
